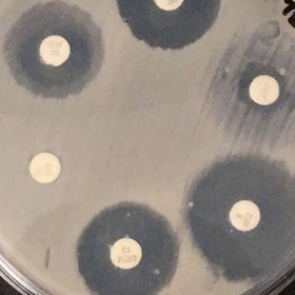
Названа неожиданная опасность уборки пыли

Журналист-выдумщик вымогал деньги для несуществующих героев 0
24 декабря 2018 - Melissa
| 1319 просмотров
Теги: сегодня, россия, новости, красноярский край, ачинск
Читать далее...
Теги: сегодня, россия, новости, красноярский край, ачинск
Литва захотела заморозить средства российских олигархов 0
20 декабря 2018 - Marishka
| 690 просмотров
Читать далее...
Япония отреагировала на размещение российских военных на Курилах 0
19 декабря 2018 - Marishka
| 655 просмотров
Читать далее...
Генассамблея ООН признала Россию угрозой для Украины 0
18 декабря 2018 - Marishka
| 632 просмотра
Читать далее...
Предсказана глобальная нехватка питьевой воды 0
14 декабря 2018 - Marishka
| 832 просмотра
Читать далее...
Названа неожиданная опасность уборки пыли 0
13 декабря 2018 - Marishka
| 663 просмотра
Читать далее...
Застрявших в Китае российских туристов начали возвращать домой 0
13 декабря 2018 - Marishka
| 649 просмотров
Читать далее...